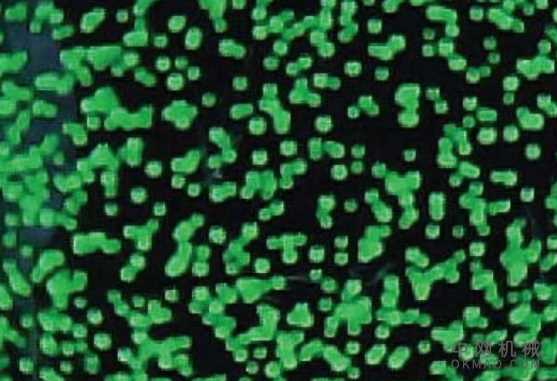
新型廉价的触觉传感器使机器人能够感觉到 中国机械网,okmao.com

在机器学习的帮助下,ETH研究人员开发了一种新颖而低成本的触觉传感器。该传感器以高分辨率和高精度测量力的分布,使机械臂能够抓住敏感或易碎的物体。

人类可以用手捡起易碎或湿滑的物体中国机械网okmao.com。我们的触觉使我们感觉到我们是否对物体有牢固的把握或它是否会滑过手指,因此我们可以相应地调整握力的强度。负责抓取易碎,打滑或表面复杂的物体的机器人抓取臂也需要这种反馈。
苏黎世联邦理工学院的机器人研究人员现在已经开发出一种触觉传感器,这种触觉传感器可以在这种情况下派上用场,并标志着他们认为朝着“机器人皮肤”迈出的重要一步。工程师指出,该传感器极其简单的设计使其生产成本低廉。从本质上讲,它由一个带有彩色塑料微珠的弹性硅树脂“皮肤”和一个固定在底面上的常规摄像头组成。
使用纯光学输入进行测量
该传感器基于视觉:与物体接触时,硅酮皮肤上会出现凹痕。这会改变微珠的图案,该图案由传感器下侧的鱼眼镜头记录。根据图案的这些变化,可以计算出力传感器上的分布。
“传统的传感器仅在一个点上记录施加的力。相比之下,我们的机器人皮肤使我们能够区分作用在传感器表面上的多个力,并以较高的分辨率和精度对其进行计算,” Carlo Sferrazza说。他是由苏黎世联邦理工学院动态系统与控制教授Raffaello D'Andrea领导的小组的博士生。“我们甚至可以确定作用力的方向,” Sferrazza说。换句话说,研究人员不仅可以识别在传感器上施加垂直压力的力,还可以识别横向作用的剪切力。
触觉传感器原型。信用:苏黎世联邦理工学院
数据驱动的开发
为了计算哪些力将微珠推向哪个方向,工程师使用了一套全面的实验数据:在通过机器控制进行标准化的测试中,他们检查了与传感器的各种不同接触。他们能够精确地控制并系统地改变接触的位置,力的分布以及接触物体的大小。在机器学习的帮助下,研究人员记录了数千个接触实例,并将它们与磁珠图案的变化精确匹配。

迄今为止,研究人员已经建立的最薄的传感器原型厚度为1.7厘米,覆盖5 x 5厘米的测量表面。但是,研究人员正在使用相同的技术来实现配备有多个摄像头的更大的传感器表面,从而也可以识别形状复杂的物体。此外,他们的目标是使传感器更薄-他们相信使用现有技术可以实现仅0.5厘米的厚度。
机器人,运动与虚拟现实
由于弹性硅树脂是防滑的,并且传感器可以测量剪切力,因此非常适合用于机器人抓手臂。Sferrazza解释说:“当物体威胁要滑出手臂的抓地力时,传感器会识别出来,以便机器人可以调整其抓地力。”
信用:苏黎世联邦理工学院
研究人员还可以使用这种传感器来测试材料的硬度或数字化触摸图。如果集成到可穿戴设备中,骑自行车的人可以通过踏板测量他们对自行车施加的力,或者跑步者可以测量在慢跑时进入鞋中的力。最后,这种传感器可以提供对于开发例如虚拟现实游戏的触觉反馈重要的信息。